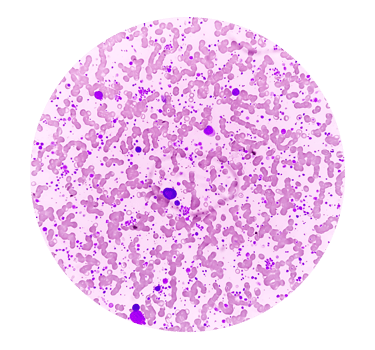
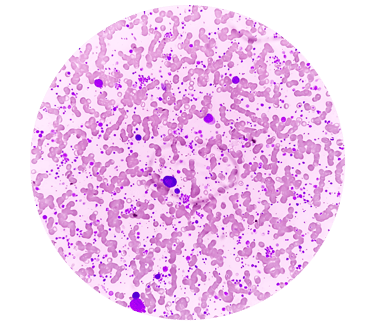

Dr. Mario Enrique Alvarez Bojórquez
ALTA ESPECIALIDAD EN ONCOLOGÍA TORÁCICA
Conoce al Dr. Mario E. Alvarez Bojórquez
FORMACIÓN ACADÉMICA
CÉDULA PROFESIONAL 7624303
ESPECIALIDAD EN CIRUGIA GENERAL
Instituto Mexicano del Seguro Social.
Hospital Regional #1 IMSS.
Certificación por el Consejo Mexicano de Cirugía General del 2021 al 2016.
CÉDULA PROFESIONAL 10188023
SUBESPECIALIDAD EN CIRUGÍA ONCOLÓGICA
Instituto Nacional de Cancerología
Universidad Nacional Autónoma de México.
Certificación por el Consejo Mexicano de Oncología del 2019 al 2024.
CÉDULA PROFESIONAL 11503815
ALTA ESPECIALIDAD EN ONCOLOGÍA TORÁCICA
Instituto Nacional de Cancerología
Universidad Nacional Autónoma de México.
Marzo 2019 - Febrero 2020
CERTIFICACIÓN EN CIRUGÍA ROBÓTICA
INTUITIVE
Certificación en Tecnología da Vinci.
Mayo, 2022


Confianza total
Excelencia médica
Certificaciones



He recibido diversas distinciones a lo largo de mi trayectoria, entre las que destacan:
Segundo promedio más alto de la generación 2005-2009 de la Licenciatura en Medicina de la Universidad de Sonora.
Mención Honorífica en el Curso de Especialización Médica en Cirugía General en el Hospital Regional #1 en Ciudad Obregón, Sonora.
Jefe de Residentes del Instituto Nacional de Cancerología durante el periodo 1 de marzo de 2018 y el 28 de febrero de 2019.
Asimismo, tuve la oportunidad de realizar dos estancias en el extranjero:
En Tokio, Japón, donde recibí entrenamiento clínico en el Departamento de Cirugía Gástrica del Hospital del Instituto del Cáncer de JFCR durante el periodo 29 de octubre y el 22 de noviembre de 2018; y otra en Tucson, Arizona, Estados Unidos, durante el verano de 2008, donde participé en el programa "English Communication for Medical Professionals" y en el "2008 Intercambio Médico Arizona-Sonora" en la University of Arizona College of Medicine.
Mi experiencia
MIEMBRO ACTIVO DE:
Miembro Sociedad Mexicana de Oncología.
Miembro de la Asociación Mexicana de Cirugía General.
Miembro de la Society of Surgical Oncology.
Miembro de la International Association for the Study of Lung Cancer.
PRODUCCIÓN CIENTÍFICA:
Myogenic Differentiation as a Prognostic Factor in Dedifferentiated Retroperitoneal Sarcomas.